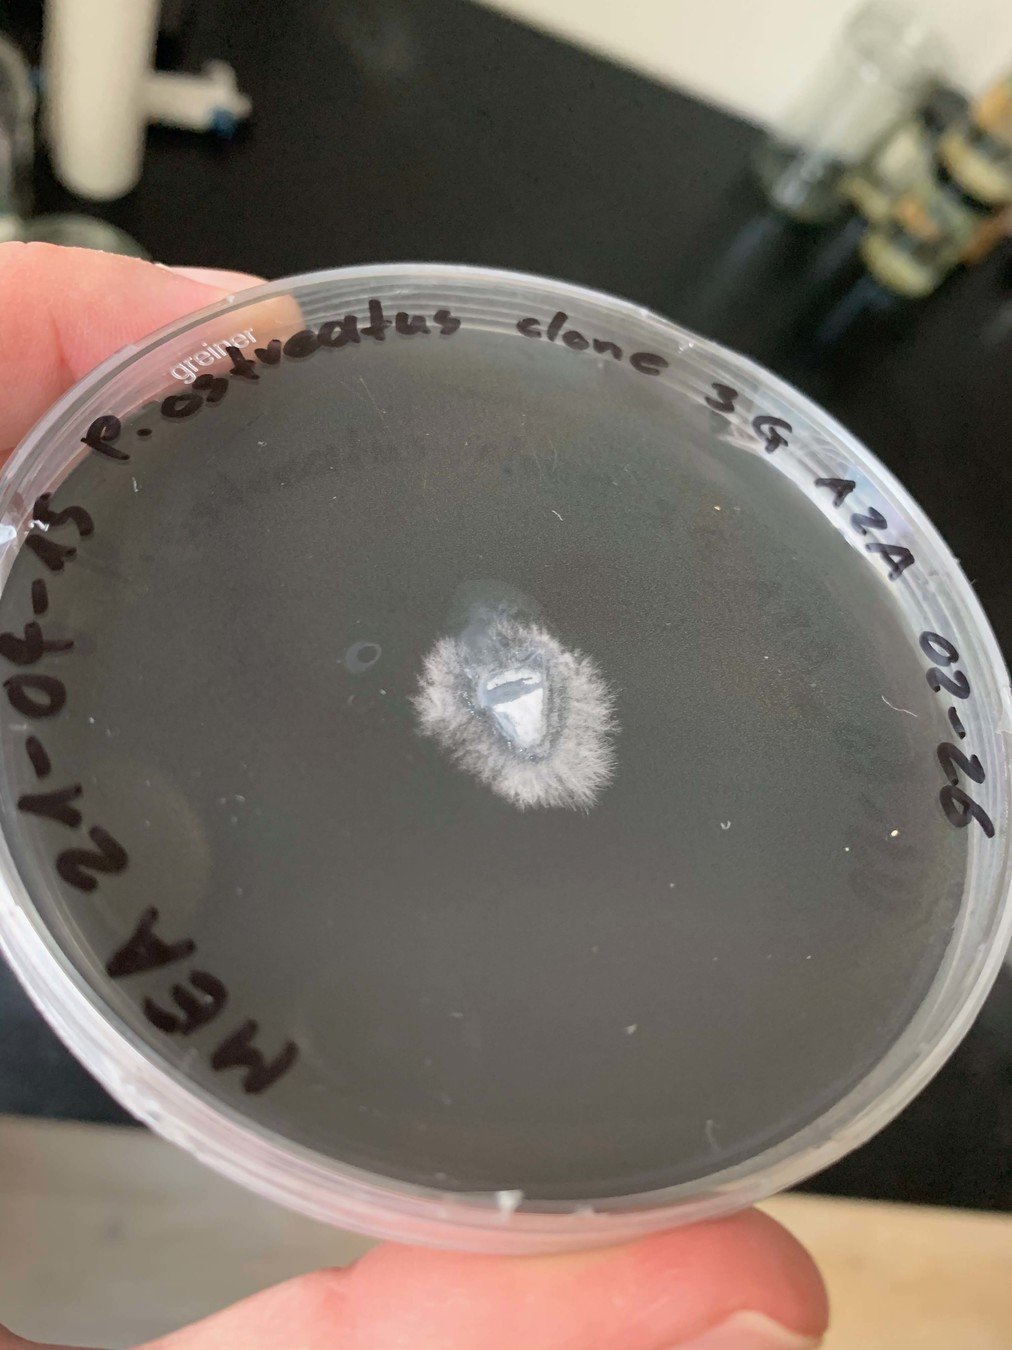

BA Thesis – Progress 3
By Colin Schmid
BA Thesis – Progress 3
A short presentation of my observations and lessons learned for my BA diploma during my sixth bachelor semester in Interaction Design at ZHdK. Mentors where Dr. Joëlle Bitton, Stella Speziali and Luke Franzke. Thanks to Dr. Ivano Brunner.